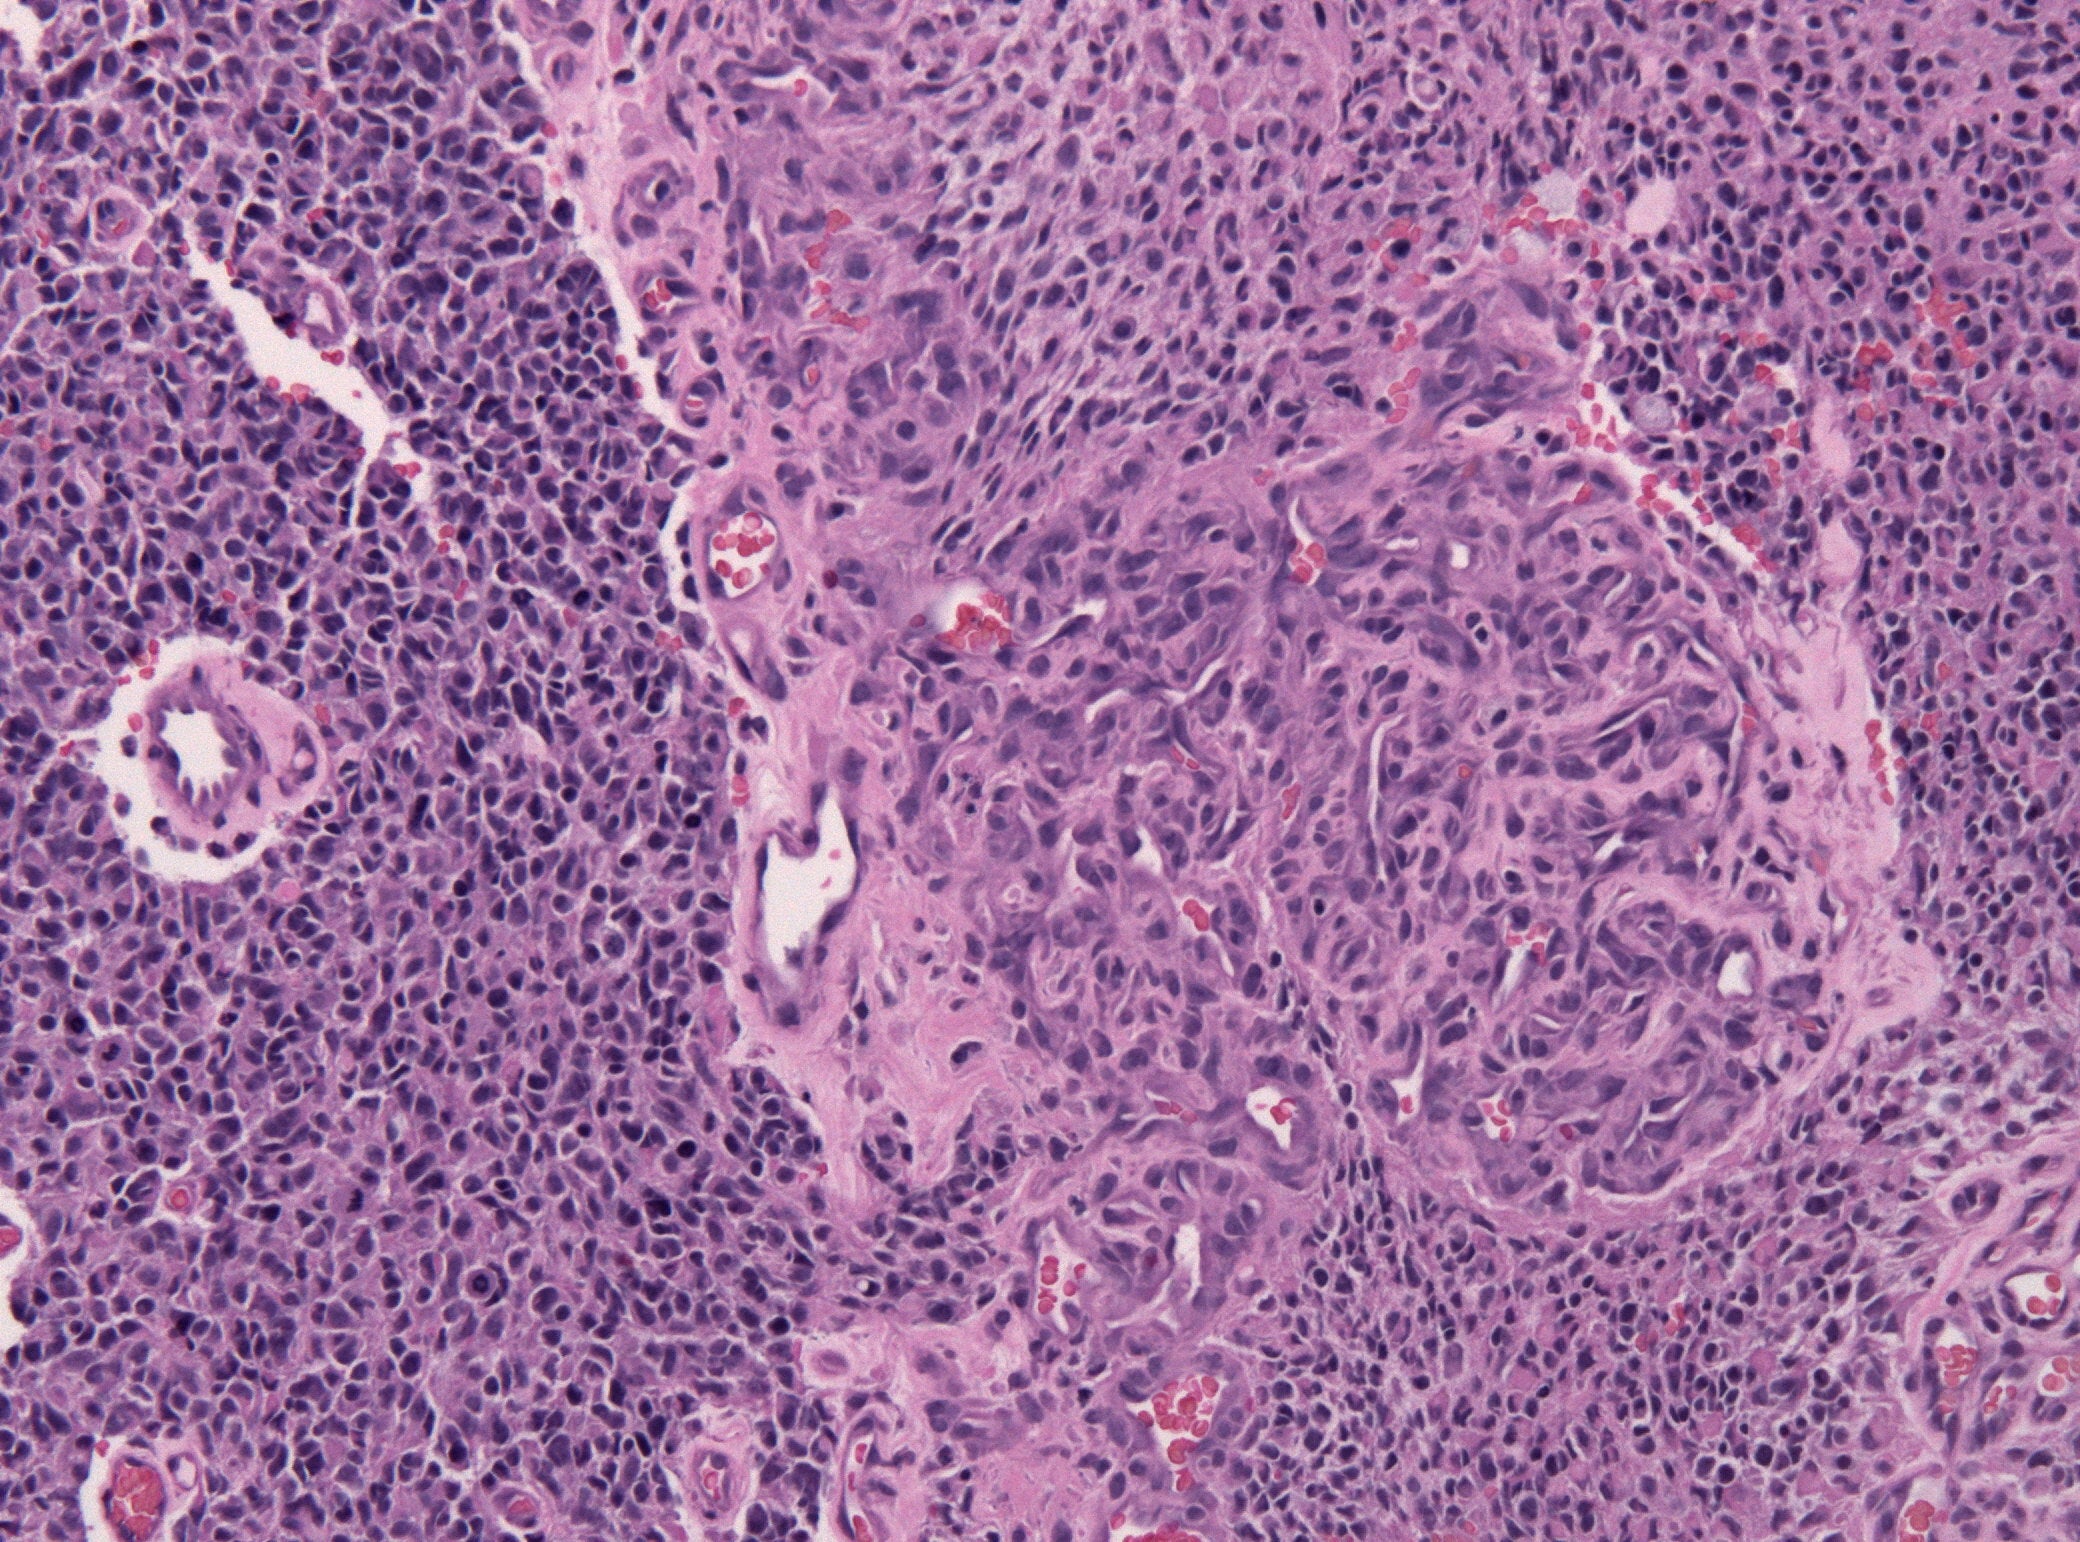

Микроинвазивный рак матки
Микроинвазивный рак матки 106 фото
Теория божественного повеления является универсальной для
Первый торпедный катер
Методы обучения с греческого означают
По каким методикам лучше
Черный маникюр стемпинг
Шиммер шайн джины
Отменить запрет вызова
Вариант 30001 информатика
Масло семян горчицы
Жк ленинградский сайт
Король орел 3 слово
Иов многострадальный читать
Пошла с мужем на массаж
Опосредованный иммунный ответ
Телефон с топовой камерой
Удивленный ежик
Результаты аккредитации через госуслуги
Моу сош краснопартизанского
Резонатор газель 405 евро 2
Как очистить машинку lg